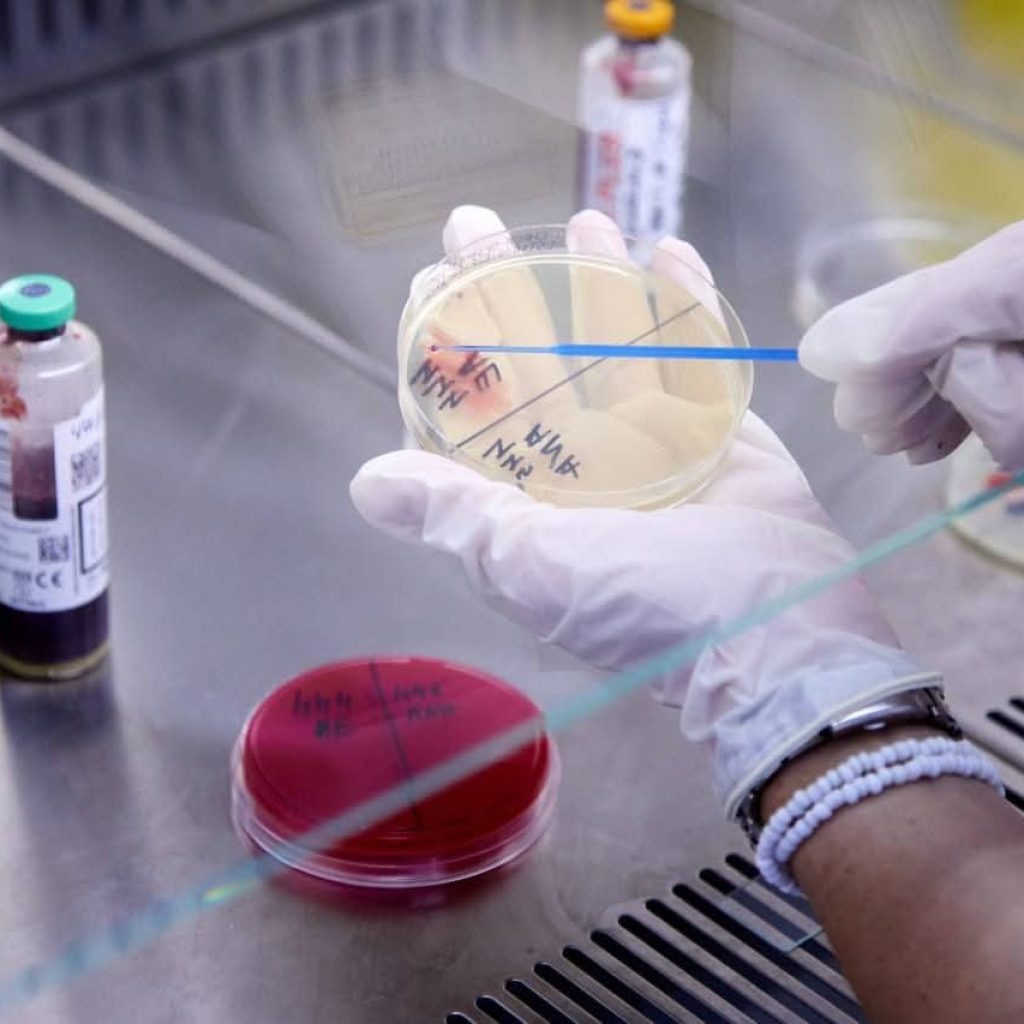

Іран офіційно підтвердив отримання американського плану врегулювання конфлікту, проте заперечує факт проведення прямих переговорів із Вашингтоном. Міністр закордонних справ Ірану Аббас Арагчі заявив, що контакти відбуваються виключно через посередників і мають формат обміну повідомленнями, а не повноцінного діалогу. Водночас Дональд Трамп стверджує, що Тегеран «відчайдушно» шукає шляхів для завершення чотиритижневої війни, яка вже призвела до ліквідації верховного лідера Алі Хаменеї та поранення його наступника.
За даними дипломатичних джерел, США передали Ірану пропозицію з 15 пунктів, яка включає вимоги щодо скорочення ядерної програми, обмеження ракетних розробок та припинення підтримки регіональних проксі-груп. Посередником у процесі виступає Пакистан, який намагається запобігти подальшій ліквідації іранських високопосадовців. Попри дипломатичні зусилля, Ізраїль зберігає скептицизм і наполягає на своєму праві завдавати превентивних ударів навіть у разі підписання будь-яких угод.
Ситуація на Близькому Сході продовжує тиснути на світові ринки: ціни на нафту відновили стрімке зростання, а фондові індекси демонструють падіння на тлі сумнівів у швидкому перемир’ї. Для адміністрації Трампа конфлікт стає серйозним політичним викликом, адже низькі рейтинги та відсутність підтримки ударів по Ірану серед американців створюють додаткову напругу напередодні виборів до Конгресу. Світ завмер в очікуванні відповіді Тегерана.